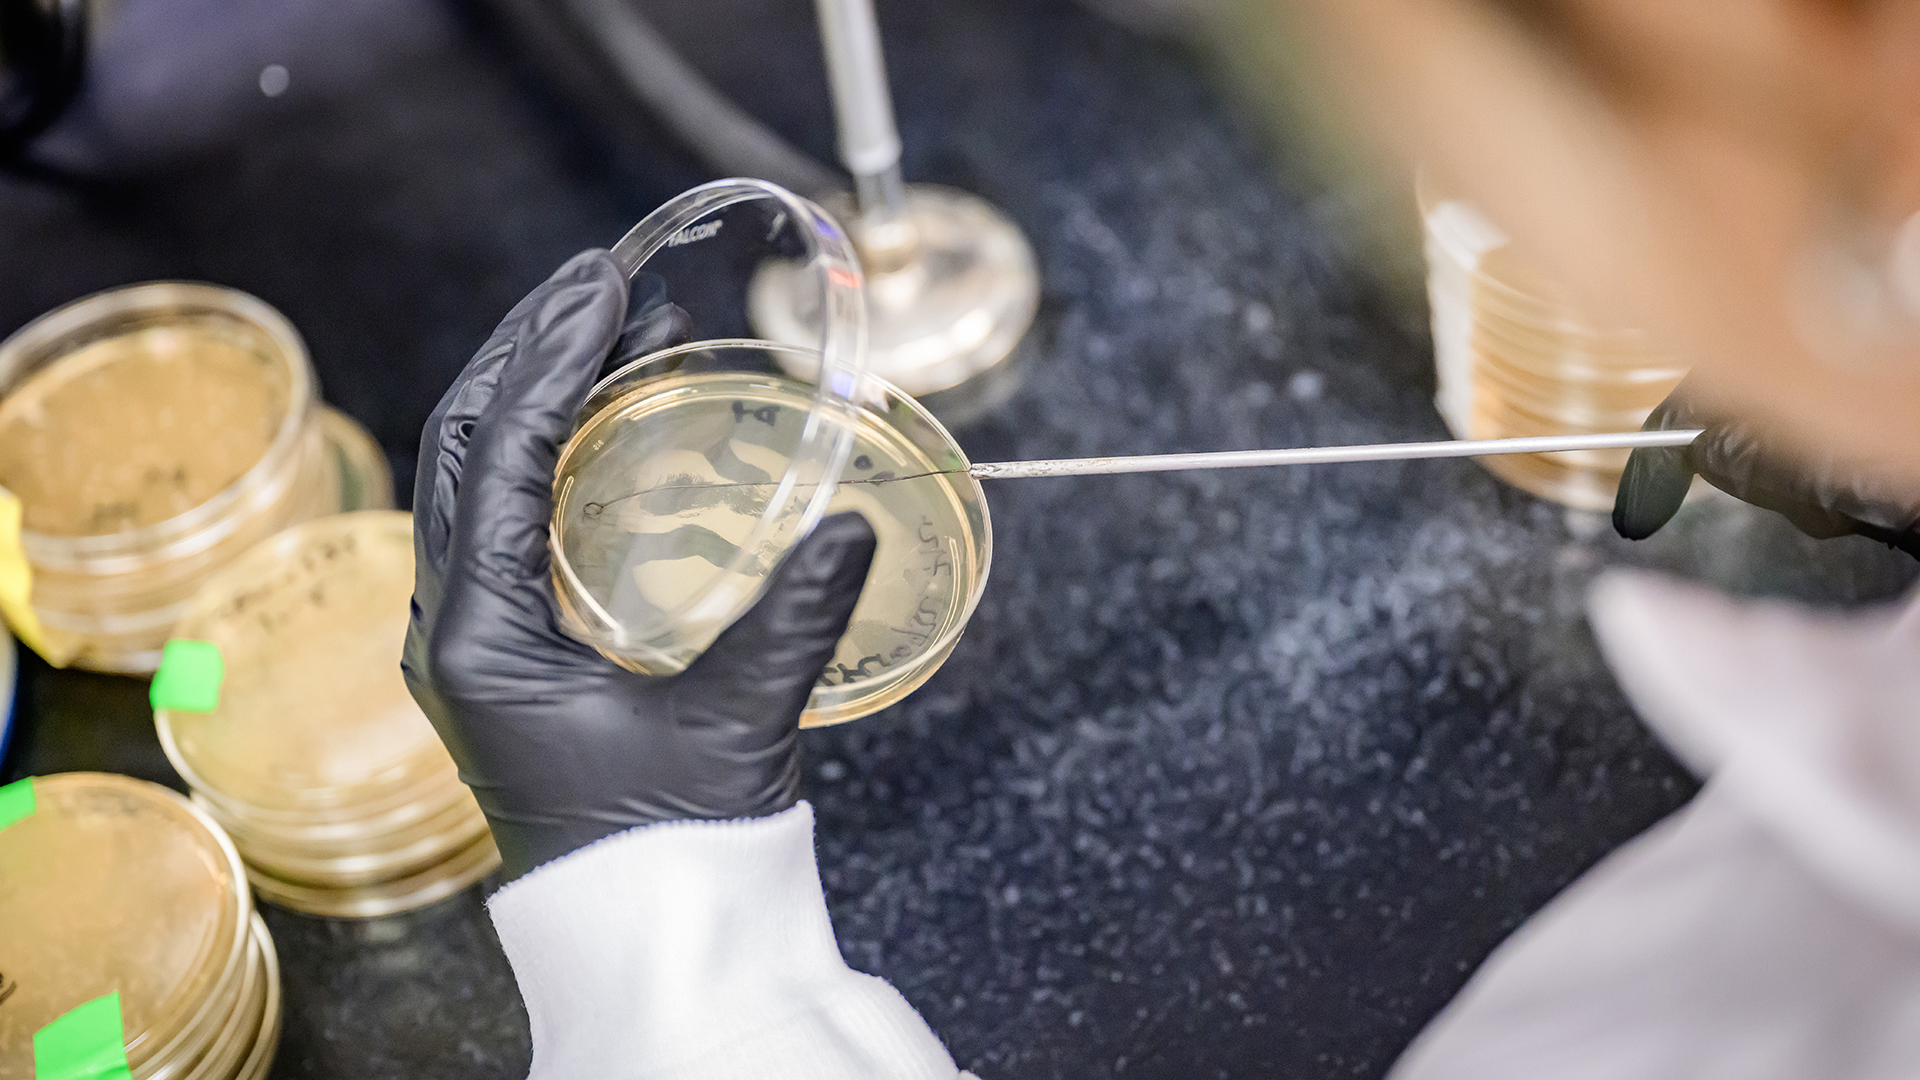
Taking samples for Gaulke lab.

Research
Our current interests
Join Our TeamFour Areas of Activity in the Lab

Defining the role of the microbiome in modulating impacts of environmental exposures on human health.
Humans are bombarded with thousands of nutritional, chemical, and microbial exposures every day. The gut microbiota interacts extensively with these exposuresimpacting both host and microbial physiology. My lab uses computational, molecular and microbiological techniques to dissect the mechanism that underpin these interactions. Our ongoing projects are examining the impacts of environmentally relevant concentrations of pesticides on the microbiome and how these impact risk of metabolic diseases, inflammatory disorders, and cancers.


Quantifying interactions between viruses, bacteria and their hosts
In contrast to the huge volume of information on the microbiome interactions with bacteria pathogens, little is known about how these communities interact with viruses. With our collaborators at UIUC, my lab is working to define the contribution of gut and respiratory microbiomes to host resistance to respiratory viral infection. Our work indicates that disruption of microbial communities during influenza and porcine reproductive and respiratory syndrome virus infections link with negative health outcomes in infection and that microbiome composition prior to infection may impact viral pathogenesis. Our ongoing leverages our preliminary findings to explore using probiotic strains to prevent infection or limit viral damage.
Evaluating the role of the gut microbiome in
gastrointestinal carcinogenesis
Disruption of gut microbial communities is a consistent feature of gut cancers suggesting that dysbiosis may contribute to gastrointestina carcinogenesis. Working with our clinical collaborators at Oregon Health and Science University we have identified diet linked predictive signatures of mucosal microbiome disruption in very early stages of colorectal cancer. Our ongoing clinical work is investigating the potential of dietary interventions to shift mucosal microbial communities to a composition that promotes health and antagonizes carcinogenesis. We have also built collaborations with investigators at the Cancer Center at Illinois to build pre- clinical animal model systems that enable us to interrogate the successional changes in microbial communities during colorectal and hepatocellular carcinogenesis.


Exploring gut microbial exposure ecology
A growing body of literature has identified the microbiome as a vital player in mediation of exposure impacts on host health. However, most work to date has focused on singular exposures in healthy adult animals over short durations. We are exploring how factors such as age, sex, and exposure duration shape microbiome resistance, resilience, and metabolic responses to singular and mixed chemical exposures. These experiments are helping to identify populations more sensitive to exposure and are uncovering the fundamental biological processes that underpin host associated microbial community responses to toxicants.